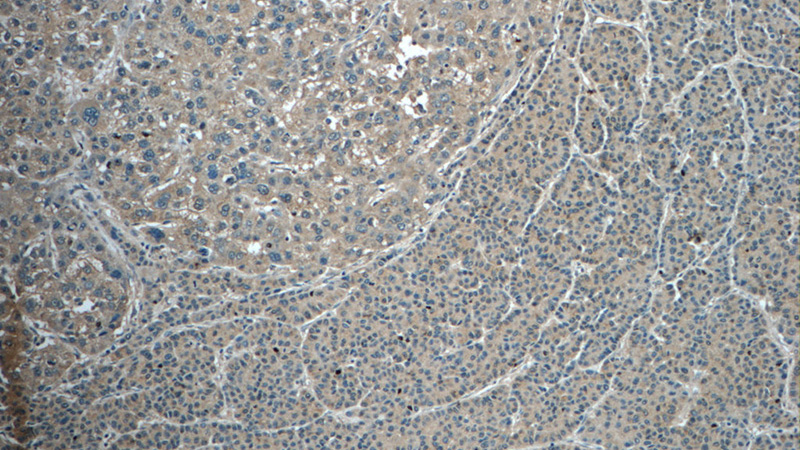
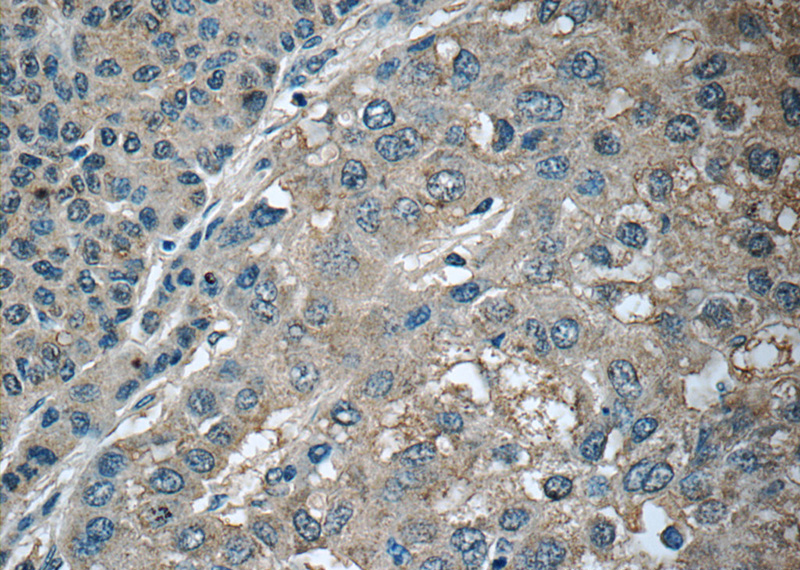

-
Product Name
CXCL12 antibody
- Documents
-
Description
CXCL12 Rabbit Polyclonal antibody. Positive IHC detected in human liver cancer tissue, human tonsillitis tissue.
-
Tested applications
ELISA, IHC
-
Species reactivity
Human, Mouse; other species not tested.
-
Alternative names
C X C motif chemokine 12 antibody; CXCL12 antibody; hIRH antibody; hSDF 1 antibody; IRH antibody; PBSF antibody; SCYB12 antibody; SDF 1 antibody; SDF 1a antibody; SDF 1b antibody; SDF1 antibody; SDF1A antibody; SDF1B antibody; Stromal cell derived factor 1 antibody; TLSF a antibody; TLSF b antibody; TPAR1 antibody
-
Isotype
Rabbit IgG
-
Preparation
This antibody was obtained by immunization of CXCL12 recombinant protein (Accession Number: NM_199168). Purification method: Antigen affinity purified.
-
Clonality
Polyclonal
-
Formulation
PBS with 0.1% sodium azide and 50% glycerol pH 7.3.
-
Storage instructions
Store at -20℃. DO NOT ALIQUOT
-
Applications
Recommended Dilution:
IHC: 1:20-1:200
-
Validations
Immunohistochemistry of paraffin-embedded human liver cancer tissue slide using Catalog No:109637(CXCL12 Antibody) at dilution of 1:50 (under 10x lens)
Immunohistochemistry of paraffin-embedded human liver cancer tissue slide using Catalog No:109637(CXCL12 Antibody) at dilution of 1:50 (under 40x lens)
-
Background
In adulthood, CXCL12 plays an important role in angiogenesis by recruiting endothelial progenitor cells (EPCs) from the bone marrow through a CXCR4 dependent mechanism (PMID: 17878755). It is this function of CXCL12 that makes it a very important factor in carcinogenesis and the neovascularisation linked to tumour progression (PMID: 16943240). CXCL12 also has a role in tumor metastasis where cancer cells that express the receptor CXCR4 are attracted to metastasis target tissues that release the ligand, CXCL12 (PMID: 11242036 ). In breast cancer, however, increased expression of CXCL12 determines a reduced risk of distant metastasis (PMID: 19646861; 17724466 ).
-
References
- Yang S, Yang TS, Wang F, Su SB. High-mobility group box-1-Toll-Like receptor 4 axis mediates the recruitment of endothelial progenitor cells in alkali-induced corneal neovascularization. International immunopharmacology. 28(1):450-8. 2015.
Related Products / Services
Please note: All products are "FOR RESEARCH USE ONLY AND ARE NOT INTENDED FOR DIAGNOSTIC OR THERAPEUTIC USE"
